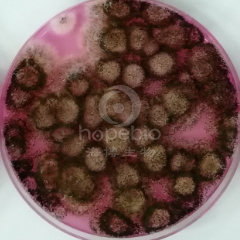
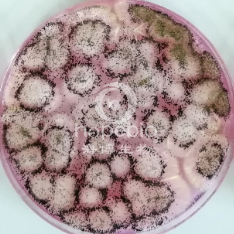
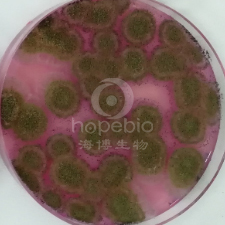
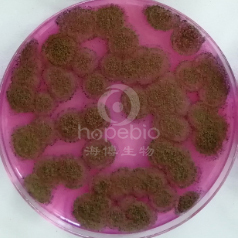
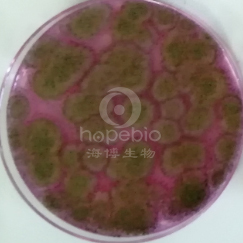
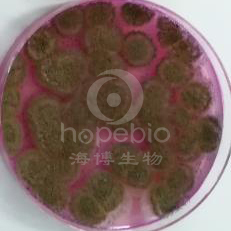
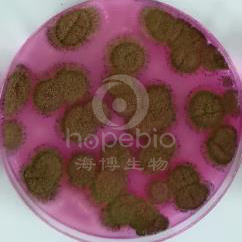
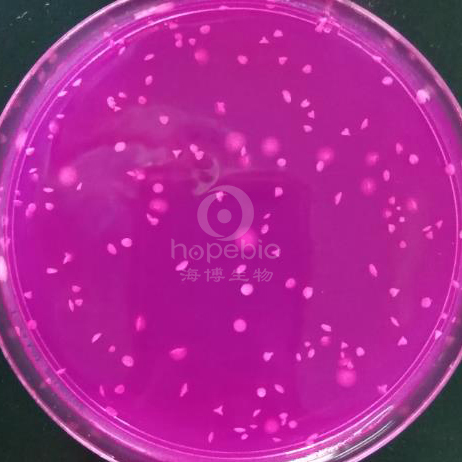
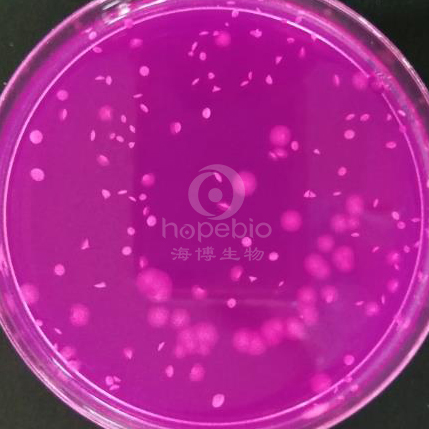
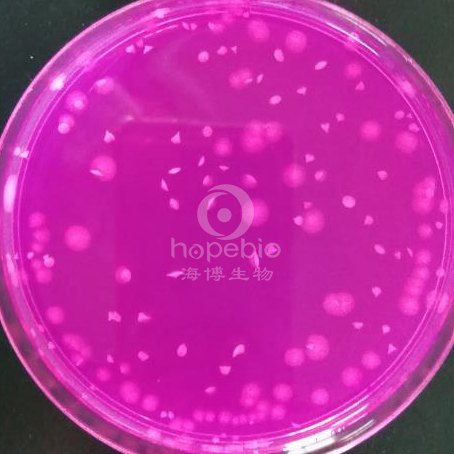
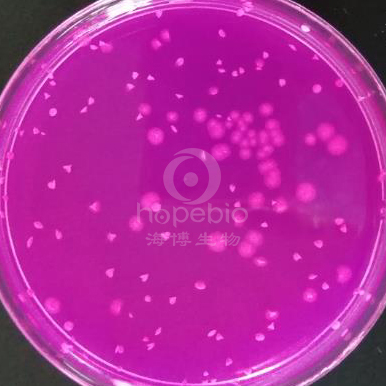

海博微信公众号
海博微信公众号
 海博天猫旗舰店
海博天猫旗舰店


 海博微信公众号
海博微信公众号
 海博天猫旗舰店
海博天猫旗舰店




一、孟加拉红培养基用途
用于食品中霉菌和酵母菌总数的测定。
霉菌(Mould)是非分类学名词,是对菌丝体发达,而又不产生大型肉质子实体的丝状真菌的俗称。按照Smith分类系统,霉菌分属于真菌界、子囊菌纲和半知菌类。在自然界分布广泛,无所不在,而且种类和数量惊人。霉菌的菌落大、疏松、干燥、不透明,有的呈绒毛状或絮状或网状,菌体可沿培养基表面蔓延生长,由于不同的真菌孢子含有不同的色素,所以菌落可呈现红、黄、绿、青绿、青灰、黑、白、灰等多种颜色。
酵母(Yeast)是非分类学术语,泛指能发酵各种糖类的各种单细胞真菌,不同的酵母菌在进化和分类地位上有异源性。一些酵母菌能够通过出芽的方式进行无性生殖,也可以通过形成孢子的形式进行有性生殖。目前已知有500多种酵母,大部分被分类到子囊菌门。
霉菌和酵母菌可以造成许多食物的腐败,原因在于霉菌和酵母菌宽泛的环境适应力。大多数霉菌和酵母菌是专性需氧菌,需要游离氧气进行生长。对酸碱度要求较低,从pH值2.0到高于pH值9.0均可生长。生长温度范围10℃~35℃,最适生长温度25℃~28℃。
二、培养基配方(g/L):
|
蛋白胨 |
5.0 |
|
葡萄糖 |
10.0 |
|
磷酸二氢钾 |
1.0 |
|
硫酸镁 |
0.5 |
|
孟加拉红 |
0.033 |
|
氯霉素 |
0.1 |
|
琼脂 |
20.0 |
三、培养基原理
蛋白胨作为培养基中的营养物质,提供菌体生长所需的氮源等;葡萄糖提供微生物生长所需的碳源,自然界中大多数微生物都能利用葡萄糖,由于细菌代谢过程中分解代谢葡萄糖产酸,培养及加热灭菌时葡萄糖被破坏焦化,因此应注意其用量及灭菌时间和温度;磷酸二氢钾作为培养基的缓冲剂;硫酸镁能够促进菌体细胞的生长;孟加拉红可抑制细菌的生长,也可抑制繁殖过快的霉菌菌落的大小和高度,此外还可作为着色剂,霉菌或酵母菌吸收后便于菌落的观察;氯霉素作为抗生素可抑制细菌的生长;琼脂为培养基的凝固剂。
四、质控菌株
在GB4789.28-2013培养基和试剂的质量要求中关于孟加拉红培养基的质量控制标准如下表所示:
表1孟加拉红培养基的质量控制标准
|
质控菌株 |
菌株编号 |
参比或计数培养基 |
方法 |
质控结果 |
其他特征 |
|
酿酒酵母 |
ATCC 9763 |
SDA |
定量 |
PR≥0.7 |
奶油色菌落 |
|
黑曲霉 |
ATCC 16404 |
SDA |
定量 |
PR≥0.7 |
白色菌丝,黑色孢子 |
|
大肠埃希氏菌 |
ATCC 25922 |
/ |
半定量 |
G≤1 |
/ |
|
金黄色葡萄球菌 |
ATCC 6538 |
/ |
半定量 |
G≤1 |
/ |
为了更好地对培养基进行质量控制,从实验室中选取5株酿酒酵母和7株黑曲霉、6株大肠埃希氏菌和8株金黄色葡萄球菌进行检验。
具体菌株信息如下表所示:
表2孟加拉红培养基的质控菌株
|
菌株名称 |
菌株编号 |
菌株名称 |
菌株编号 |
|
酿酒酵母 |
ATCC 9763 |
黑曲霉 |
ATCC 16404 |
|
CMCC 98017 |
CMCC 98020 |
||
|
CMCC 98018 |
CMCC 98021 |
||
|
CMCC 98019 |
CMCC 98022 |
||
|
CMCC 98023 |
|||
|
CICC 1425 |
CMCC 98024 |
||
|
CICC 2089 |
|||
|
大肠埃希氏菌 |
ATCC 25922 |
金黄色葡萄球菌 |
ATCC 6538 |
|
CMCC 43201 |
CMCC 26302 |
||
|
CMCC 43203 |
CMCC 26305 |
||
|
CMCC 43204 |
CMCC 26304 |
||
|
CMCC 43205 |
CMCC 26307 |
||
|
CMCC 26306 |
|||
|
CICC 24652 |
CICC 10145 |
||
|
CICC 10790 |
五、培养基质控检验方法:
1.称取本品36.6g,加热搅拌溶解于1000mL蒸馏水中,分装三角瓶,121℃高压灭菌15分钟,冷却至45-50℃备用;
2.将新活化的目标菌(酿酒酵母和黑曲霉)用生理盐水进行10倍梯度系列稀释;吸取适宜稀释度的质控菌液1mL加入至无菌空平皿中,加入约10-15mL孟加拉红琼脂摇匀,凝固后覆盖约5mL孟加拉红琼脂,每株菌接种3个平板,同时倾注3个SDA平板做参比培养基计数,待培养基凝固;
3.挑取非目标菌(大肠埃希氏菌和金黄色葡萄球菌)至TSB试管中,过夜培养;使用1μL接种环挑取1环菌液,划六线接种于孟加拉红琼脂平板,每株菌接种3个平板;
4.将平板倒置于恒温培养箱内,28±1℃需氧培养5d,记录试验结果。
六、培养基质控试验结果
1.7株黑曲霉在孟加拉红培养基上28±1℃需氧培养5d后,均有黑色孢子产生,回收率在90%以上。
|
|
|
|
黑曲霉ATCC 16404 |
黑曲霉CICC 2089 |
黑曲霉CMCC 98020 |
|
|
|
|
|
|
|
|
黑曲霉CMCC 98021 |
|
黑曲霉CMCC 98022 |
|
黑曲霉CMCC 98023 |
|
黑曲霉CMCC 98024 |
2.5株酿酒酵母在孟加拉红培养基上28±1℃需氧培养5d后,为奶白色菌落,回收率均在90%以上。
 |
|
|
酿酒酵母CICC 1425 |
酿酒酵母ATCC 9763 |
|
|
|
|
酿酒酵母CMCC 98017 |
酿酒酵母CMCC 98018 |
酿酒酵母CMCC 98019 |
3.本培养基要求抑制大肠埃希氏菌和金黄色葡萄球菌的生长,大肠埃希氏菌和金黄色葡萄球菌在培养基上划六线28±1℃需氧培养5d后,均未生长,符合标准要求,计数菌株生长指数G值结果如下表所示:
表3非目标菌生长指数G值计数结果
菌株名称
菌株编号
孟加拉红培养基
平皿1
平皿2
平皿3
大肠埃希氏菌
ATCC 25922
0
0
0
CMCC 43201
0
0
0
CMCC 43203
0
0
0
CMCC 43204
0
0
0
CMCC 43205
0
0
0
CICC 24652
0
0
0
金黄色葡萄球菌
ATCC 6538
0
0
0
CMCC 26302
0
0
0
CMCC 26305
0
0
0
CMCC 26304
0
0
0
CMCC 26307
0
0
0
CMCC 26306
0
0
0
CICC 10145
0
0
0
CICC 10790
0
0
0
七、参考文献
[1]GB 4789.28-2013 食品微生物学检验 培养基和试剂的质量要求.
[2]GB 4789.15-2016 食品安全国家标准 食品微生物学检验 霉菌和酵母计数.
[3]赵贵明. 微生物培养基及其原材料质量控制. 北京中国标准出版社,2018.1.
相关产品:
注:本文属海博生物原创,未经允许不得转载。
上一篇:乳酸酚棉蓝染色液原理和使用方法
下一篇:霍乱双糖铁琼脂实验原理及现象



